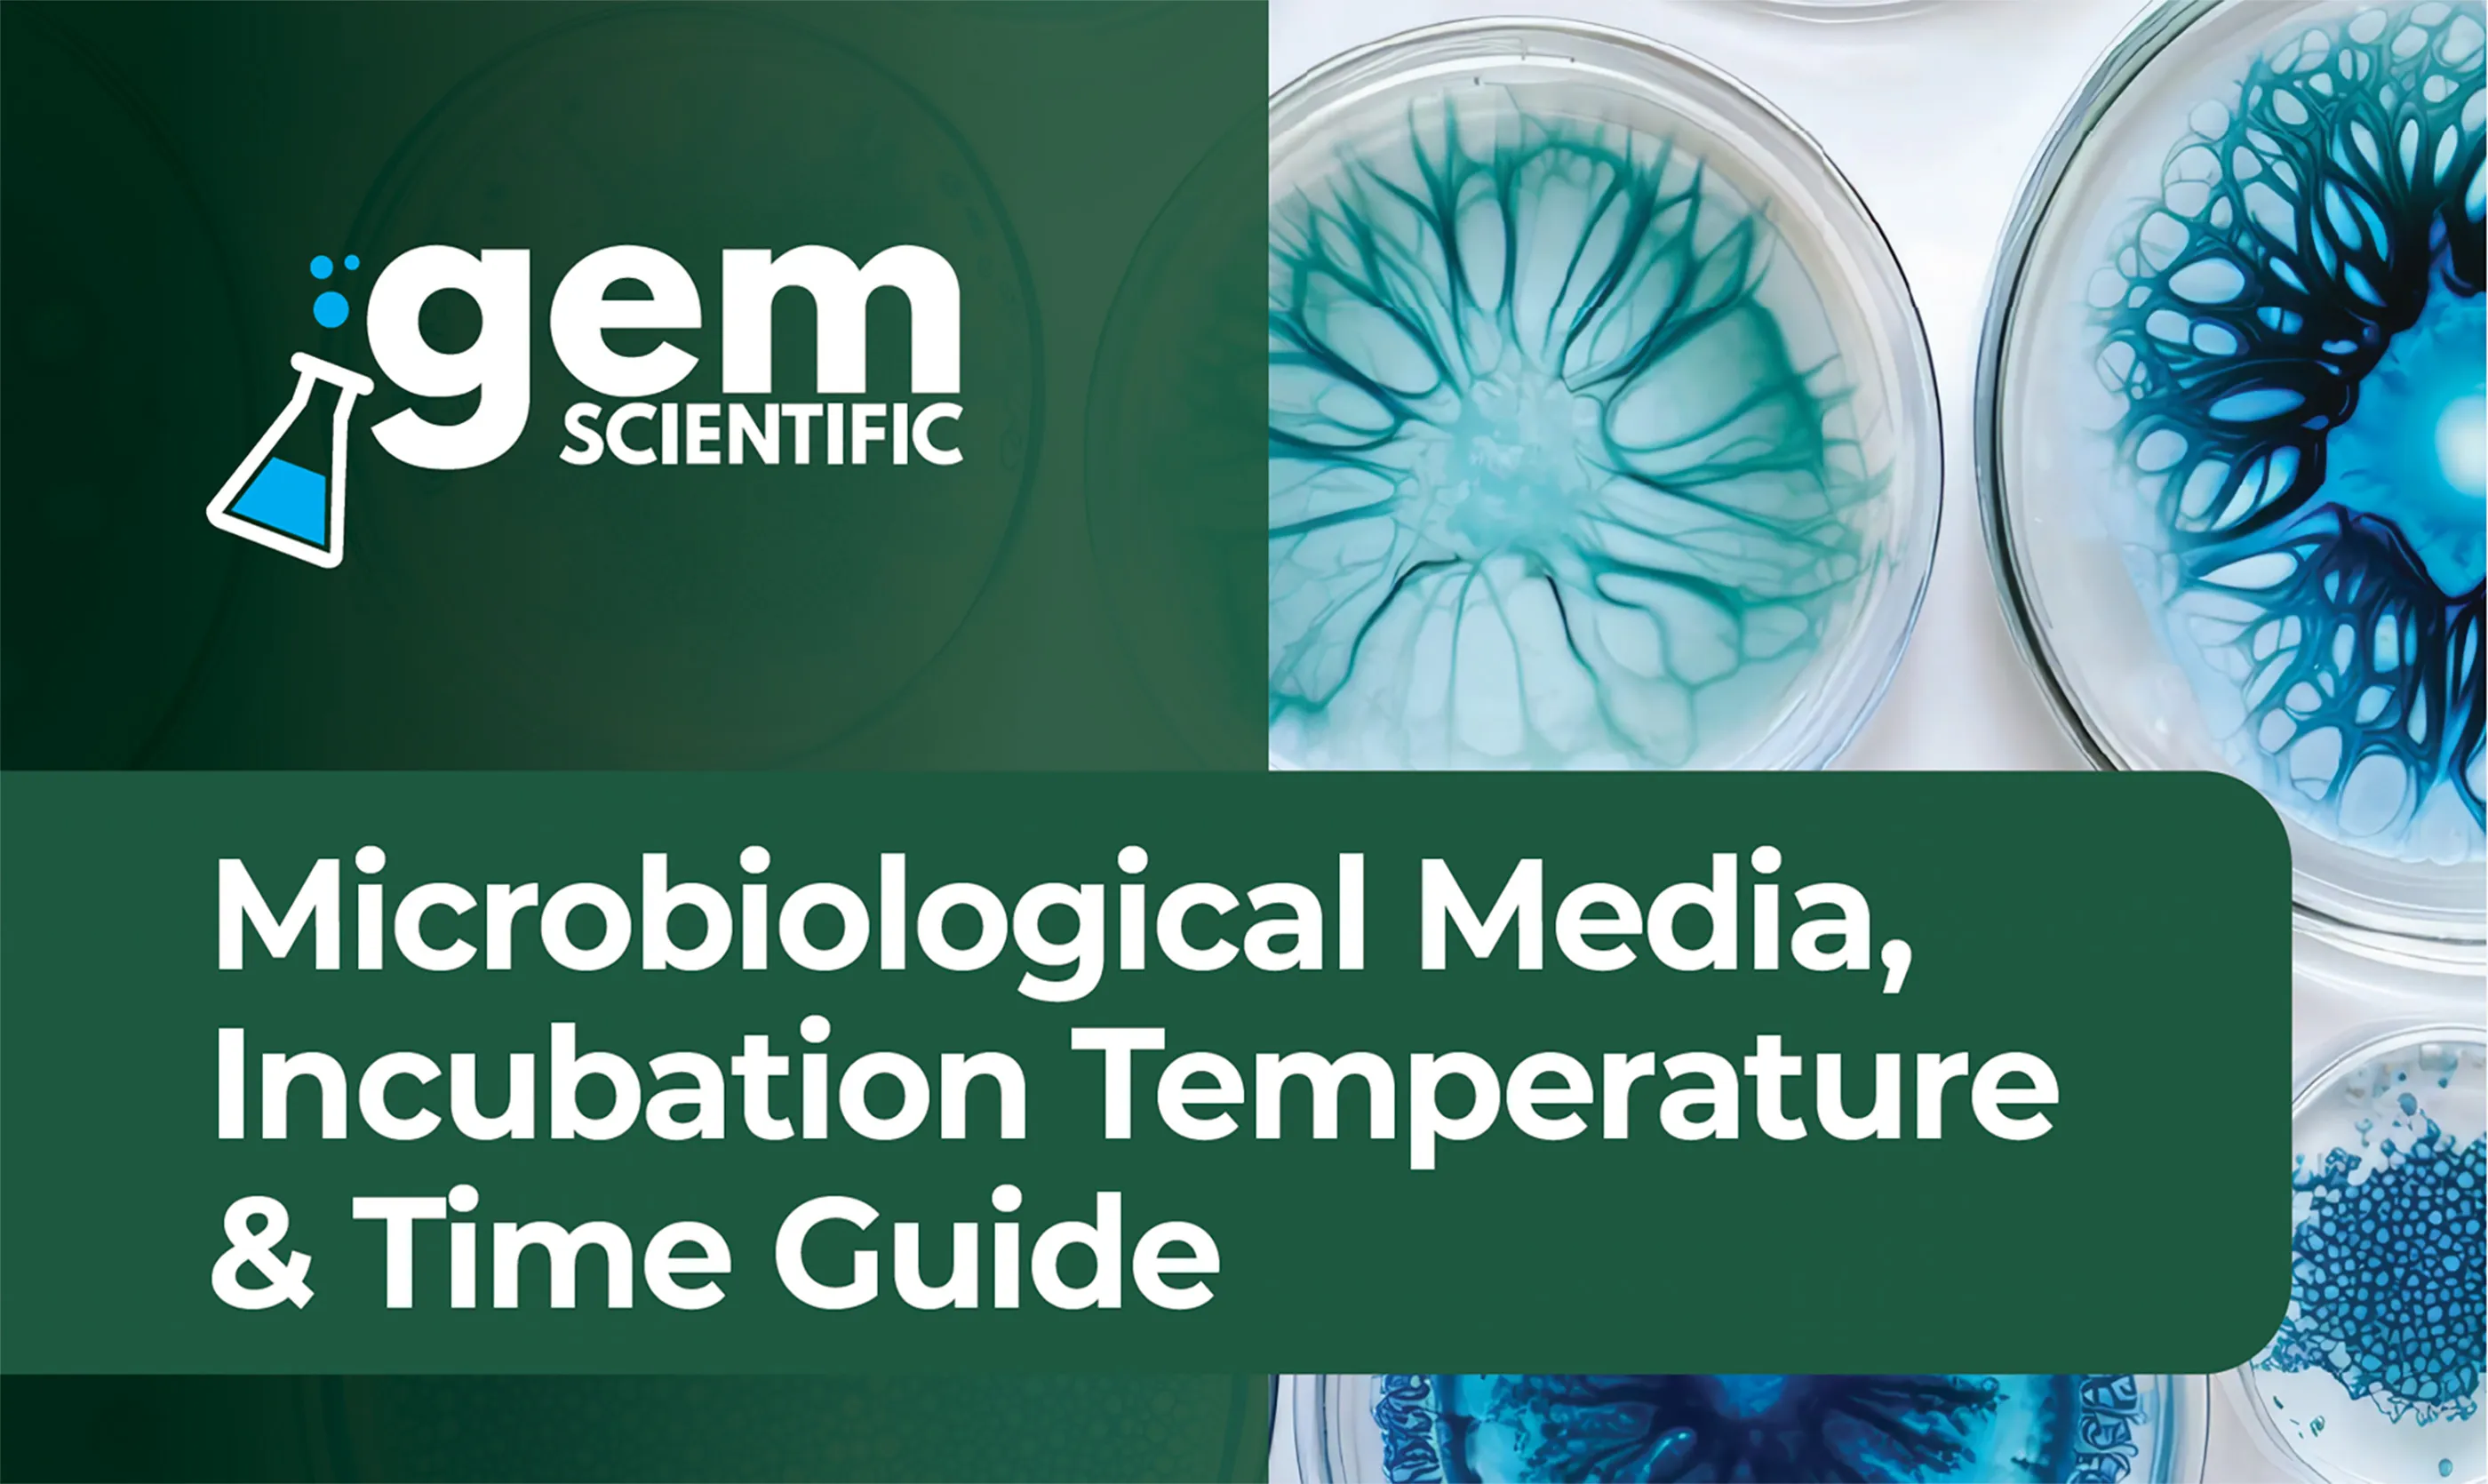

-
Hygiene Monitoring
add remove
- Luminometers
- Hygiena® EnSURE™ Touch
- Hygiena® SystemSURE™
- Neogen® Clean-Trace™ LM1
- Surface ATP Swabs
- Hygiena® SuperSnap®
- Hygiena® UltraSnap®
- Neogen® Clean-Trace™
- ATP Water Swabs
- Hygiena® AquaSnap® Total ATP Water
- Hygiena® AquaSnap® Free ATP Water
- Neogen® Clean-Trace™ Water - Total ATP
- Neogen® Clean-Trace™ Water - Free ATP
-
Diagnostic Tests
add remove
-
Lab Equipment
add remove
- Autoclaves add remove
- Balances & Weighing Equipment add remove
- Blenders & Homogenisers
- Homogenisers
- Stomachers
- Cabinets add remove
- Centrifuges add remove
- Colony Counters & Molecular Detection
- Gas Analysis & Monitoring add remove
- Glass Washers
- Hotplates & Stirrers add remove
- Incubators add remove
- Inspection Equipment
-
Meters
add remove
- Anemometers
- Conductivity Meters
- Damp Meters
- Density Meters
- Dissolved Oxygen Meters
- Electrodes & Probes
- Hydrometers
- Hygrometers
- Ion Specific Meters
- Kits
- Meter Accessories
- Moisture/Damp Meters
- Multi-parameter Meters
- pH Meters
- Pocket/Portable Meters
- Pressure Meters
- Salinity Meters
- Turbidity Meters
- Viscometers
- Microscopes add remove
- NIR Instruments
- Ovens add remove
- Photometers
- Handheld Photometers
- Spectrophotometers
- Refractometers
- Refrigeration & Freezers add remove
- Rotary Evaporators add remove
- Shakers, Rockers & Mixers add remove
- Thermometers add remove
- Titrators add remove
- Water Baths add remove
-
Lab Consumables
add remove
- Bottles & Containers add remove
- Buffers, Reagents & Chemicals add remove
- Cuvettes, Tubes & Vials
- Detectable Consumables add remove
- Disinfectants & Decontaminants add remove
- Electrodes & Probes add remove
- Probes & Accessories
- Filtering & Dispensers add remove
-
Brands
add remove
-
- 100% Chef
- A&D
- Adam Equipment
- AGC
- Analox
- Aqualab
- Asecos
- Astell
- Astell Scientific
- Atago
- Aurora Scientific
- Barky
- BD
- Bellingham & Stanley
- Binder
- Biochrom
- BRAND
- BST
- Buchi
- C.Gerhardt
- Clearline
- Clifton by Nickel Electro
- Clifton Food Range
- Cole Parmer
- Cole-Parmer
- CoolMed
- Corning
- Dansensor
- Decon
- Delvo
- E&O Labs
- Eppendorf
- Esco
- ETI
- EUTECH
- Funke Gerber
- Gem Scientific
- Genesys
- Genlab
- Geotech
- Gilson
- GILSON SCIENTIFIC
- GiroVap
- Grant Instruments
- Greiner Bio-One
- Guest Medical
- GVS Filter Technology
- Hach
- Haier Biomedical
- Hanna Instruments
- HeroLab
- Honeywell
- Horiba
- Hydrosense
- Hygiena®
- IDEXX
- IK
- IKA
- InnovaPrep
- Integra
- Jaytec
- Jenway
- JIM Engineering
- Johnson Analytica
- KNF
- Labcold
- Liebherr
- LMS
- Lovibond
- Lynd Products
- Medline Scientific
- Merck
- Meter
- Mettler Toledo
- Miele
- Milwaukee Instruments
- Minebea Intec
- Monmouth Scientific
- Motic
- MSE
- MWE
- Neogen®
- Nordic Labs
- Ohaus
- Olympus
- Oxoid
- PDI
- Prestige Medical
- Priorclave
- Purite
- Pyrex
- QMP
- Rotronic
- S. Murray & Co
- Sampling Systems
- Sartorius
- Schaller
- SciMed
- Seward
- SGL
- SLS
- SLS Chemicals
- Solotech
- Solus
- Special Ingredients
- Sterilin
- Steris
- Stomacher
- Stuart
- Sychem
- Testo
- Thermo Electron LED
- Thermo Scientific
- TSC
- Turbovac
- Unigloves
- Veolia Water Purification Systems
- Vikan
- Virkon
- Vorwerk
- Waters
- Whirl-Pak
- WTW
- Xylem
- YSI
- Zahm and Nagel
- Zeulab
-
- New Products & Offers add remove
-
Knowledge Hub
add remove Knowledge Hub add removeMIXOLOGY add remove
FREE DELIVERY OVER £200 IS APPLIED AUTOMATICALLY AT CHECKOUT**
Close arrow_back
-
Hygiene Monitoring
add remove
- Luminometers
- Hygiena® EnSURE™ Touch
- Hygiena® SystemSURE™
- Neogen® Clean-Trace™ LM1
- Surface ATP Swabs
- Hygiena® SuperSnap®
- Hygiena® UltraSnap®
- Neogen® Clean-Trace™
- ATP Water Swabs
- Hygiena® AquaSnap® Total ATP Water
- Hygiena® AquaSnap® Free ATP Water
- Neogen® Clean-Trace™ Water - Total ATP
- Neogen® Clean-Trace™ Water - Free ATP
-
Diagnostic Tests
add remove
-
Lab Equipment
add remove
- Autoclaves add remove
- Balances & Weighing Equipment add remove
- Blenders & Homogenisers
- Homogenisers
- Stomachers
- Cabinets add remove
- Centrifuges add remove
- Colony Counters & Molecular Detection
- Gas Analysis & Monitoring add remove
- Glass Washers
- Hotplates & Stirrers add remove
- Incubators add remove
- Inspection Equipment
-
Meters
add remove
- Anemometers
- Conductivity Meters
- Damp Meters
- Density Meters
- Dissolved Oxygen Meters
- Electrodes & Probes
- Hydrometers
- Hygrometers
- Ion Specific Meters
- Kits
- Meter Accessories
- Moisture/Damp Meters
- Multi-parameter Meters
- pH Meters
- Pocket/Portable Meters
- Pressure Meters
- Salinity Meters
- Turbidity Meters
- Viscometers
- Microscopes add remove
- NIR Instruments
- Ovens add remove
- Photometers
- Handheld Photometers
- Spectrophotometers
- Refractometers
- Refrigeration & Freezers add remove
- Rotary Evaporators add remove
- Shakers, Rockers & Mixers add remove
- Thermometers add remove
- Titrators add remove
- Water Baths add remove
-
Lab Consumables
add remove
- Bottles & Containers add remove
- Buffers, Reagents & Chemicals add remove
- Cuvettes, Tubes & Vials
- Detectable Consumables add remove
- Disinfectants & Decontaminants add remove
- Electrodes & Probes add remove
- Probes & Accessories
- Filtering & Dispensers add remove
-
Brands
add remove
-
- 100% Chef
- A&D
- Adam Equipment
- AGC
- Analox
- Aqualab
- Asecos
- Astell
- Astell Scientific
- Atago
- Aurora Scientific
- Barky
- BD
- Bellingham & Stanley
- Binder
- Biochrom
- BRAND
- BST
- Buchi
- C.Gerhardt
- Clearline
- Clifton by Nickel Electro
- Clifton Food Range
- Cole Parmer
- Cole-Parmer
- CoolMed
- Corning
- Dansensor
- Decon
- Delvo
- E&O Labs
- Eppendorf
- Esco
- ETI
- EUTECH
- Funke Gerber
- Gem Scientific
- Genesys
- Genlab
- Geotech
- Gilson
- GILSON SCIENTIFIC
- GiroVap
- Grant Instruments
- Greiner Bio-One
- Guest Medical
- GVS Filter Technology
- Hach
- Haier Biomedical
- Hanna Instruments
- HeroLab
- Honeywell
- Horiba
- Hydrosense
- Hygiena®
- IDEXX
- IK
- IKA
- InnovaPrep
- Integra
- Jaytec
- Jenway
- JIM Engineering
- Johnson Analytica
- KNF
- Labcold
- Liebherr
- LMS
- Lovibond
- Lynd Products
- Medline Scientific
- Merck
- Meter
- Mettler Toledo
- Miele
- Milwaukee Instruments
- Minebea Intec
- Monmouth Scientific
- Motic
- MSE
- MWE
- Neogen®
- Nordic Labs
- Ohaus
- Olympus
- Oxoid
- PDI
- Prestige Medical
- Priorclave
- Purite
- Pyrex
- QMP
- Rotronic
- S. Murray & Co
- Sampling Systems
- Sartorius
- Schaller
- SciMed
- Seward
- SGL
- SLS
- SLS Chemicals
- Solotech
- Solus
- Special Ingredients
- Sterilin
- Steris
- Stomacher
- Stuart
- Sychem
- Testo
- Thermo Electron LED
- Thermo Scientific
- TSC
- Turbovac
- Unigloves
- Veolia Water Purification Systems
- Vikan
- Virkon
- Vorwerk
- Waters
- Whirl-Pak
- WTW
- Xylem
- YSI
- Zahm and Nagel
- Zeulab
-
- New Products & Offers add remove
-
Knowledge Hub
add remove Knowledge Hub add removeMIXOLOGY add remove